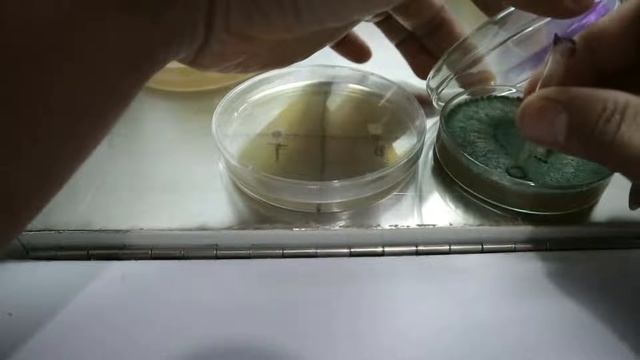
Apa Bisa Trichoderma Dan Beauveria Aplikasi Bersamaan? смотреть онлайн

Автор / Канал: Лесная мечта Страница 2

Fudge paint box blueberry hill review =^.^=

Курица в сливках на садже рецепт курицы с чесноком и грибами

What is the Penicillium|Introduction, Occurrence, vegetative structure, reproduction| Botany For Yo

inside the black

Шайни- Yeyo♡. Speed up

The Ring 65 SP

New Superbug Outbreak, "Candida Auris," Channel 3 Eyewitness News

простые числа A2 1 рус

чёрная пантера

Recording #424

Biology Chapter 2 Biological Classification part 17 Fungi types Phycomycetes, Ascomycetes CBSE cla

mga dahon na pangpainit sa kabuteng saging

"НЕНАВИЖУ, но ЛЮБЛЮ" ТАТЬЯНА ЧУБАРОВА #красивыепесниолюбви#бальзамлюбви#красивыепесниолюбви#ЛОРЕН

ядерный гриб
Apa Bisa Trichoderma Dan Beauveria Aplikasi Bersamaan?

Truffle training courses at MicoLab

Танки Онлайн Получения звания Рядовой!

#Кабачки как шашлык 😋👍🏾

METABOLISMO SALU I BIENESTAR...CANDIDA ALBICANS... (7 SEPT 2017)

РаКурс, вып.9 - 8-е сентября

сезон грибы.

Опять школа F

Пародия на клип// Тает лед Грибы//Пародия//Новинка2017

Black cherry truffle freshbaked fresh baked Long Beach farmers ig: cali_bud_reviews
За каждым успешным каналом стоит личность, идея и сотни часов кропотливого труда. Если вы здесь, значит, автор «Лесная мечта» уже сумел зацепить ваше внимание своим уникальным стилем или подачей. А мы на RUVIDEO позаботились о том, чтобы вы могли изучить весь архив его работ в максимально комфортных условиях — без лишней суеты и преград.
Почему за работами канала «Лесная мечта» так интересно наблюдать? Всё просто: это честный контент, который находит отклик в сердцах зрителей. На нашем ресурсе вы можете смотреть онлайн все видео любимого автора бесплатно и в хорошем качестве. Нам важно, чтобы вы видели каждую деталь и слышали каждый нюанс, поэтому мы используем только стабильные плееры из открытых источников Rutube.
Следите за новинками канала, пересматривайте старые шедевры и открывайте для себя новые грани творчества «Лесная мечта». Мы постоянно обновляем ленту, чтобы у вас под рукой всегда были самые свежие выпуски. Никаких сложных регистраций — только вы и творчество, которое вдохновляет. Приятного вам путешествия по миру авторского контента на RUVIDEO!
Видео взято из открытых источников Rutube. Если вы правообладатель, обратитесь к первоисточнику.